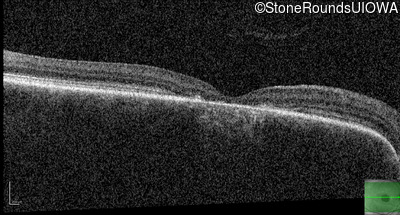
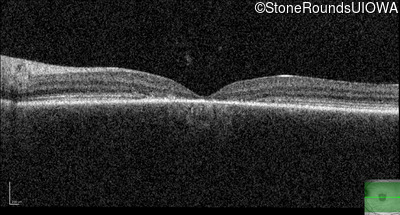

Case
SR4565
Student Mode
AD Stargardt Disease (IIF)
Male
Male
Hidden
SR4565
Student Mode
AD Stargardt Disease (IIF)
Male
Male
History
This 16 year old male was found to have 6 diopters of astigmatism OU at age 3. This was initially correctable with spectacles, but over the past year he began using his father's hand held magnifier.
Diagnosis & molecular findings
| Disease | Gene | Allele 1 variant(s) | Allele 2 variant(s) | Inheritance mode |
|---|---|---|---|---|
| AD Stargardt Disease | ELOVL4 | Leu263 del5tttCTTAA | AD |